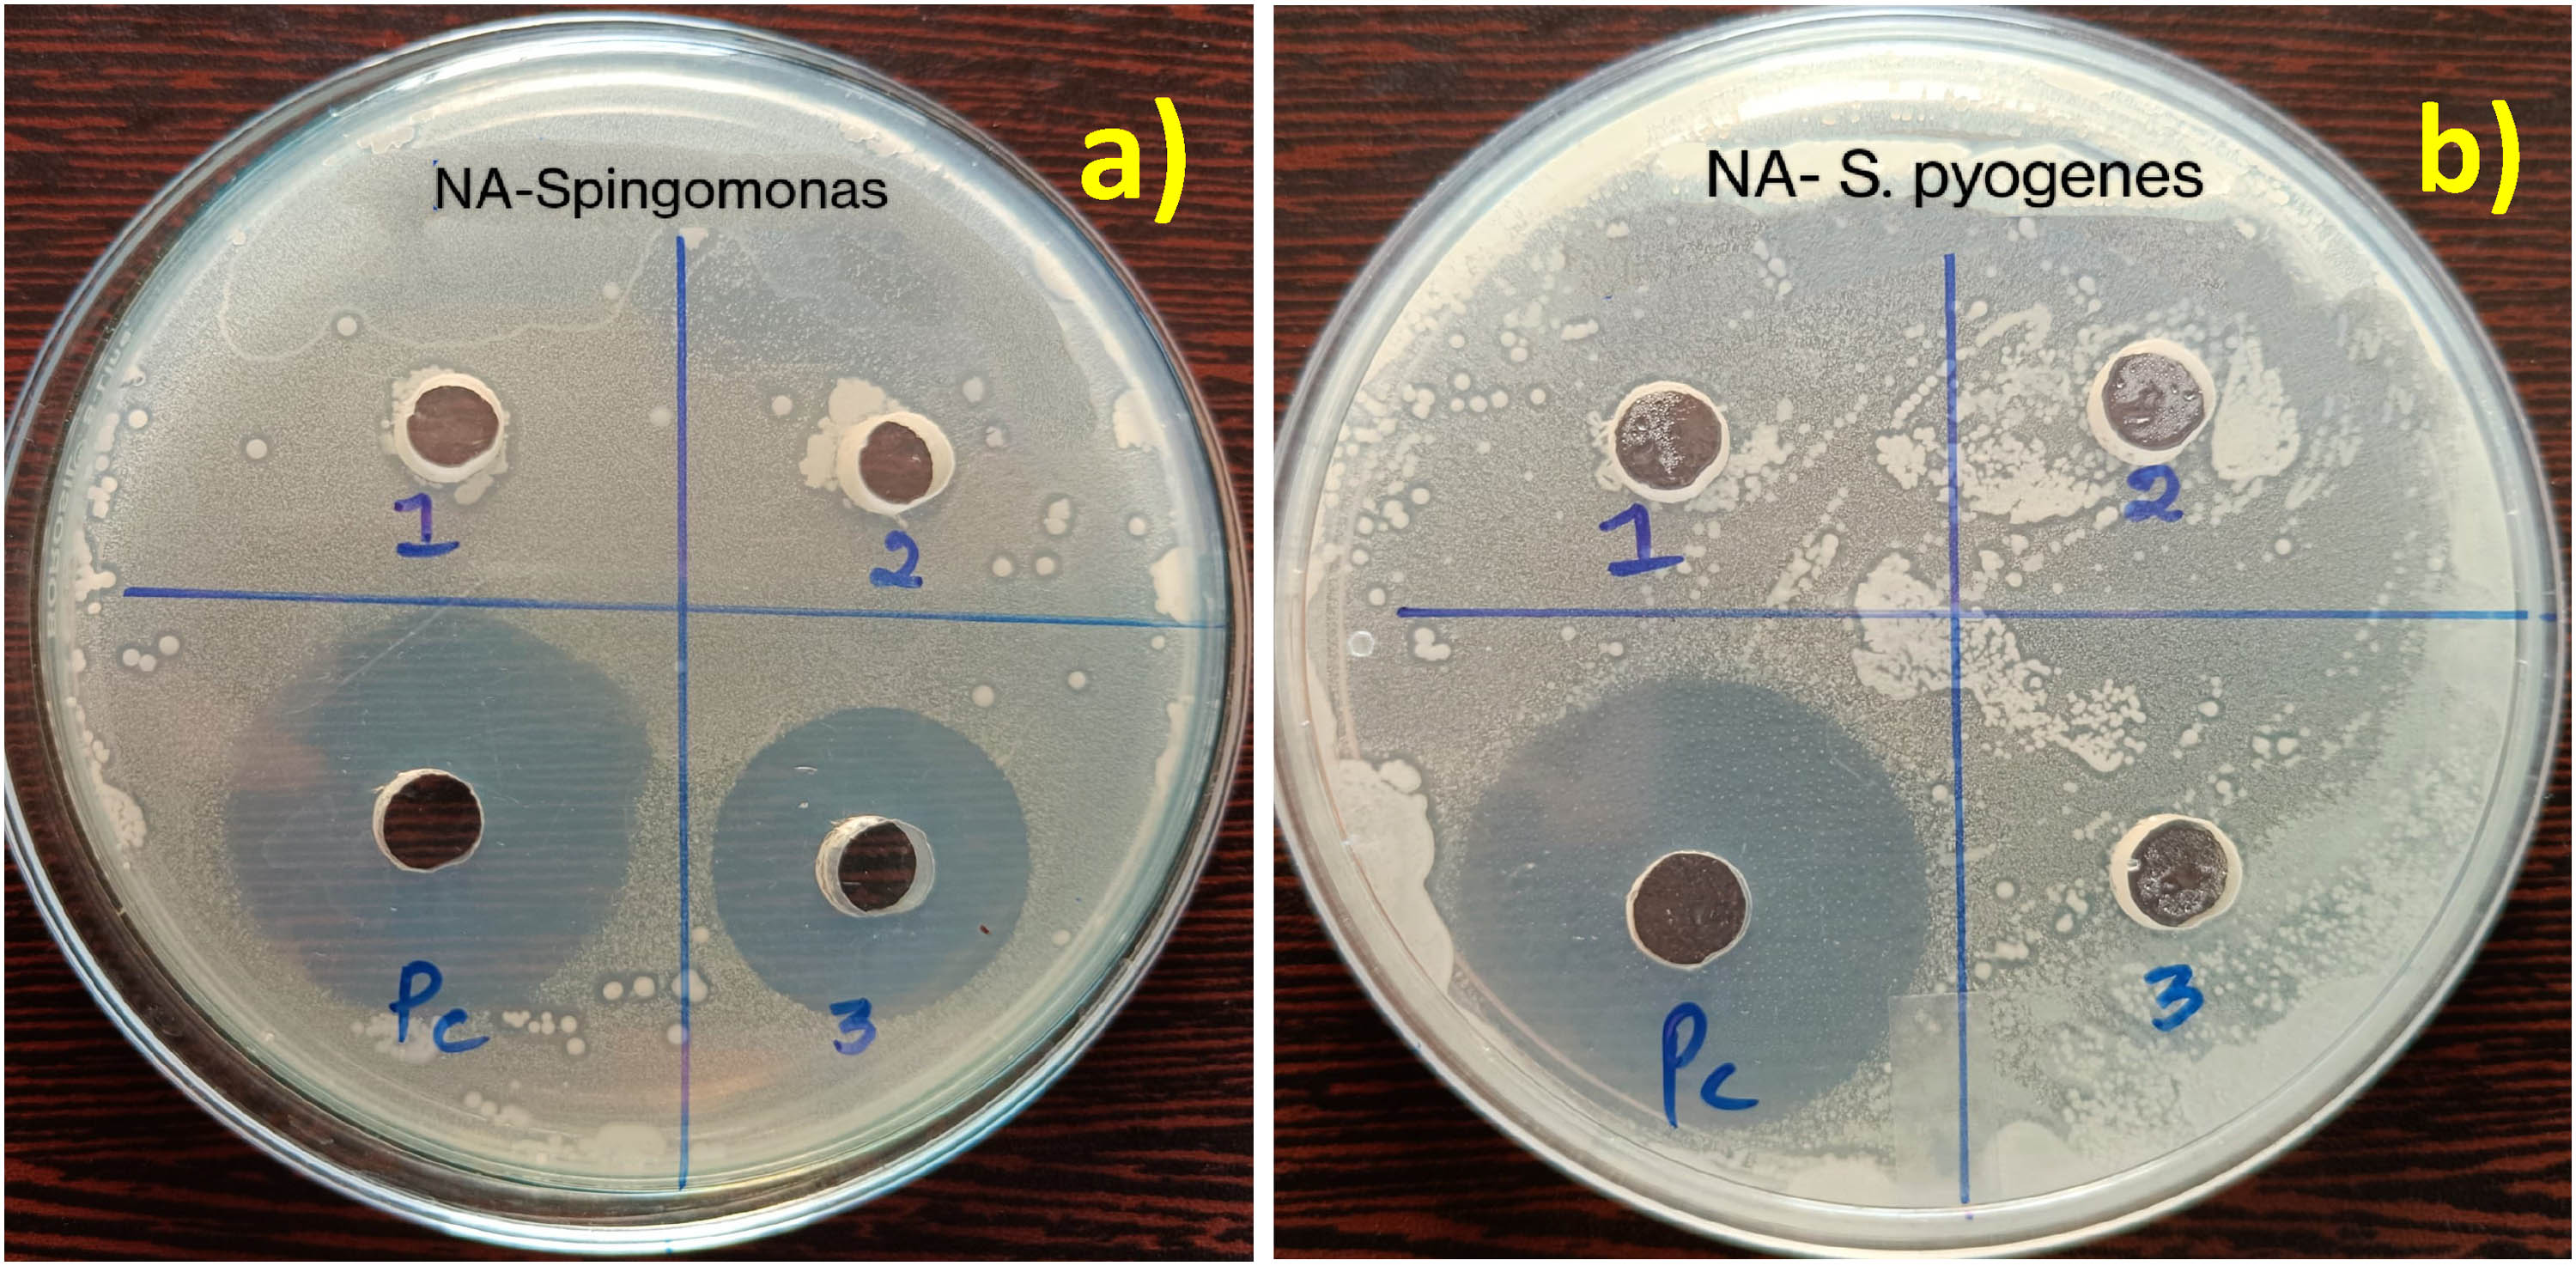
Figure 11 
                     Antibacterial properties of Co/ZnO against (a) S. pausimobilis and (b) S. pyrogenes.

Abstract
The present study explores the combustion-mediated sol–gel preparation of the cobalt-doped ZnO (Co/ZnO) nanohybrids. The characterization results of as-prepared samples were investigated using analytical instruments like FTIR, XRD, XPS, SEM, UV-Vis DRS, BET, and TGA. The doping of cobalt into ZnO was achieved at a lower particle size (21.3 nm) than the pure ZnO (29.6 nm). We observed that the Co-doped ZnO grain size seems to be in abundance and diversity than that of the undoped ZnO. Further examination was carried out with photocatalytic degradation of acid red (AR) dye under visible light illumination and antibacterial performance over Spingomonous pausimobilis and Streptococcus pyrogenes to assess the catalytic performance of the prepared Co/ZnO nanohybrid. The photocatalytic degradation results from the optimum reaction conditions are 150 mg of catalyst loading, pH 2, and 10 ppm of initial AR dye concentration, and the complete degradation of AR dye in 120 min. The antibacterial performance of the Co/ZnO nanohybrid was measured and was found to be 25 and 16 mm for S. pausimobilis and S. pyrogenes, respectively, with respect to the control chloramphenicol.
Graphical abstract

Abbreviations
- Co/ZnO
-
cobalt-doped ZnO
- XRD
-
X-ray diffraction
- SEM
-
scanning electron microscope
- FTIR
-
Fourier transform infrared spectroscopy
- XPS
-
X-ray photoelectron microscope
- TGA
-
thermogravimetric analysis
- DRS
-
diffuse reflectance spectroscopy
- BET
-
Brunauer–Emmett–Teller
1 Introduction
Transparent semiconductors containing conductive oxides provide antireflection coatings, which can help increase absorption in solar cells. Among the II–VI group of semiconductors, zinc oxide (ZnO) has a wurtzite crystal structure, a direct and wide bandgap energy of 3.37 eV, a high exciton binding energy of 60 meV, and a good optical gain at room temperature [1,2,3]. Wurtzite ZnO is used in a variety of applications, such as field-effect transistors [4], optical components [5], dye-sensitized solar cells [6], and solid-state gas sensors [7,8]. Various nanostructured materials are being researched right now to regulate light and enhance absorption in photovoltaic cells. ZnO is a potential material for optoelectronic devices because it possesses a variety of practical electrical and optical aspects. Recent research demonstrates that the defect centres and defect concentrations found in the ZnO lattice can regulate the optical, magnetic, and electrical properties of ZnO nanostructures [9,10]. Due to its comparable ionic radius, many electronic states, and divalent state, cobalt is a desirable transition metal for doping ZnO. Additionally, cobalt-doped ZnO samples have remarkable optical and magnetic properties even at low concentrations of cobalt substitution [11,12]. Sputtering, sol–gel, spin coating, solvothermal, ultrasonic spray, and pulsed laser deposition processes have all been used to create cobalt-doped ZnO thin films and nanostructures [13,14,15,16,17].
Doping with transition metals like chromium, vanadium, iron, and cobalt has also been investigated as a way to increase its photoactivity and broaden its spectrum response. Transition metals may function as shallow traps in the lattice ZnO, which would prevent photoinduced electron–hole pairs from recombining on a photocatalyst’s surface. The presence of secondary phases, such as Co3+ ions, which may coexist with Co2+ ions, is expected to have lattice defects in cobalt-doped ZnO nanohybrids. Cobalt-doped ZnO is therefore considered to be a possible choice among the transition metal in diluted magnetic semiconductors because of its abundant electron states, high solubility in the ZnO matrix, and similar ionic radius (0.58 Å) to that of Zn (0.6 Å) [18]. The photocatalytic proficiency of the synthesized catalyst was observed by visible light-induced degradation of acid red (AR) dye. AR dye is mostly used as a colouring agent in the leather and textile industries; this industrial effluent is crucial owing to its high toxicity, solubility in water, relative environmental stability, and potential for health issues [19,20]. The same photocatalytic approach was implemented for treating pathogenic bacteria, such as Gram +ve bacteria (Spingomonous pausimobilis) and Gram –ve bacteria (Streptococcus pyrogenes), which cause skin infections in human beings. Hence, cobalt-doped ZnO (Co/ZnO) nanohybrid was proposed for this study based on the aforementioned advantages for catalytic and antimicrobial activities.
2 Experimental details
2.1 Materials
Without further purification, the desirable solutions were made using double distilled water, and all the compounds used in the synthesis were of the analytical grade. Zinc acetate Zn(CH3COO)2 and cobalt chloride (CoCl2) were obtained from E-Merck (Germany); ethylene glycol, HNO3, and glycine were obtained from Himedia, India. The AR dye was obtained from Himedia, India, and utilized as a model dye pollutant. The microorganisms were received from IMT Chandigarh, India.
2.2 Synthesis of Co/ZnO nanohybrid
In order to synthesize Co/ZnO nanohybrid in wt% (ZnO0.6 CO0.4), 20 mL of CoCl2 was combined with 20 mL of ethylene glycol and 3.2 mL of HNO3 in a 150 mL Pyrex glass beaker (solution-I) with glycine as a fuel for combustion. The mixture was stirred for 15 min. The required weight% of Zn(CH3CO2)2·2H2O, 20 mL of 1,2-ethanediol, and 3.5 mL of deionized water were added to another beaker for the hydrolysis process (solution II). Solution I was vigorously mixed as Solution II was added drop by drop. A colloidal suspension was formed after solution II was fully added. This suspension was then stirred for an additional 90 min and kept in storage for 48 h. The final product was washed with water several times and dried in an oven for 8 h.
2.3 Instrumentation
Several instrumental techniques were used to analyse the crystalline size, pure phase, optical properties, morphology, thermal stability, and functional groups of the prepared materials. These included XRD (Bruker, Cu-Kα radiation in the 2θ range from 10° to 80° at a scanning rate of 2°/min), FTIR (IR Prestige 21, scan from 400–4,000 cm−1), and SEM (JEOL JSM-6700F). UV-Vis diffused reflectance spectra were recorded (Shimadzu, 2600R, wavelength scan range of 200–800 nm with BaSO4 as reference). Thermal analyses (TGA) were achieved in N2 atmosphere with a heating rate of 10°C/min using a Perkin-Elmer model 4000 instrument. Multipack 6.0A software was used to evaluate the fitting of XPS curves. The surface area and pore volume of the samples were calculated using the Brunauer–Emmett–Teller (BET) surface area analyser (model: Gemini VII 2390 series micro metrics).
2.4 Evaluation of photocatalytic performance
The photocatalytic performance of the prepared Co/ZnO nanohybrid was determined by the photocatalytic degradation of the dye pollutant AR under visible light illumination. The photoreactor used in this study consisted of a 380 W metal halide lamp with a 570 nm cut-off filter. In the beginning, 50 mL of an aqueous AR dye solution was mixed with 0.05 g of precalculated photocatalyst, and the mixture was kept in a water-cooling beaker and stirred for 30 min in dark conditions to achieve adsorption–desorption thermal equilibrium. After 30 min, the reaction beaker was exposed to the necessary quantity of light, and the samples were collected in prescribed vials at regular time intervals and measured using a UV-Vis spectrometer. The photocatalytic degradation efficiency (% DE) was determined by the following equation:
where A 0 is the initial dye absorbance and A t is the absorbance at time t of the AR dye aqueous solution.
2.5 Antibacterial activity assay
The well diffusion method was used to measure the antibacterial activity of the Co/ZnO nanohybrid against bacterial strains (S. pausimobilis and S. pyrogenes). The test organisms (18 h-old cultures) were injected with nutrient agar media and put into a Petri plate. The media on the plates were allowed to harden at room temperature. Four wells, each measuring 5 mm in diameter, were drilled onto each plate after the medium had been set. Stock solutions of the test chemical at different concentrations (200, 300, and 400 µg/mL) were made. As a result, sterile micropipettes were used to transfer 50 µg/mL of each concentration into the plate. After completion, the zone of inhibition around the well was measured in millimetres.
3 Results and discussion
3.1 Morphology and XPS analyses
Figure 1 shows the SEM images of the prepared Co/ZnO nanocatalyst. They reveal the size and distribution of the particles in the samples. Figure 1(a) and (b) exhibits the SEM images of the prepared pure ZnO, which are agglomerated with high purity, and the particle size of 39 nm was obtained from imageJ. However, the prepared nanohybrid exhibited a particle size of 31 nm and it was observed that the Co-doped ZnO grain size seems to be more abundant and diverse than that of the undoped ZnO as shown in Figure 1(c) and (d). The SEM images of all prepared samples showed the formation of crystallites of a nanometre in size; however, as the cobalt concentration was increased, there were no appreciable changes in the grain size.

SEM images of (a and b) undoped ZnO and (c and d) Co/ZnO nanohybrid.
The elemental analysis of the synthesized samples was determined by XPS. The oxidation peaks of Co/ZnO NPs are depicted in Figure 2(a)–(e). The peaks related to binding energies of C, O, Zn, and Co and the survey spectrum of Co/ZnO were revealed. The binding energies of the two peaks (Zn 2p) at 1020.7 and 1044.1 eV, were attributed to the core levels Zn 2p3/2 and Zn 2p1/2, respectively [21]. The measured energy difference, which agrees with the earlier report, was found to be 23.4 eV. As shown in Figure 2(b), which depicts the system’s cobalt valence states, the Co peaks must fit into two Gaussian peaks with various binding energy positions. The binding energies of Co 2p peaks were positioned at 794.4 and 779.2 2p3/2 eV. According to reports, the binding energy difference of Co 2p was 15.2 eV [22]. The O1s’ binding energy values were located at 529.22 eV and 530.66 and C 1s binding energies were located at 285 eV. Therefore, Co2+ can successfully replace Zn2+ in the ZnO lattice, and Co ions in the oxidation state are surrounded by O ions.

XPS spectra of (a) C 1s, (b) O 1s, (c) Zn 2p, (d) Co 2p. (e) Survey spectrum of the Co/ZnO nanohybrid.
3.2 XRD and FTIR spectral analysis
Co-doped ZnO and ZnO with XRD patterns are shown in Figure 3. Undoped ZnO and the Co/ZnO nanohybrid exhibited polycrystalline nature with copious peaks including (100), (002), (102), (110), and (004) planes, which well coincided with the previous report (JCPDS file No. 89-0510). All diffraction peaks are in agreement with the experimental data for a hexagonal ZnO wurtzite structure, demonstrating that doped Co2+ ions do not affect the crystal structure. However, as the concentration of Co2+ doping increases, the intensity of the diffraction peaks weakens and the half-peak breadth widens, suggesting that the Co2+ ions suppress the growth of ZnO particle aggregation and influence ZnO crystallization [23]. No characteristic cobalt or cobalt oxide peaks were observed in any of the patterns, which may represent that Co2+ ions have replaced Zn2+ or are present as amorphous particles. Using the Debey–Scherrer equation (D = kλ/βcos θ), the average crystalline sizes (D) of the undoped and Co-doped samples were measured. The doping of cobalt into ZnO was achieved with a lower sample size (21.3 nm) than the pure ZnO (29.6 nm). The lower-size sample may yield better photocatalytic performance over the dye pollutants and pathogens.

XRD patterns of prepared ZnO and Co/ZnO nanohybrid.
FTIR analysis was employed in this study to examine the prepared doped and undoped ZnO and quality. Figure 4 displays the FTIR spectra of cobalt-doped and pure ZnO nanoparticles. The Zn–O bond may be seen in the spectra at around 450–490 cm−1, The band at 490 cm−1 may be attributed to oxygen deficit in ZnO. The peaks located at 1,350 cm−1 are related to the ZnO surface’s C–O absorption. The carbonate that is represented by the faint absorption band at 2,367 cm−1 likely originates from the ambient CO2 during the synthesis. The large peaks located at 3,429 cm−1 are attributed to the O–H stretching mode of the hydroxyl groups, and the bending at 1,634 cm−1 is caused by the zinc carboxylate’s asymmetrical stretching [24,25]. The peak transmittance percentage in cobalt-doped ZnO was completely quenched. Together, these findings revealed the imperfections present close to the ZnO surface. The absence of any further peaks in the spectra supports the conclusion that the final products are ZnO nanoparticles.

The FTIR spectral image of the prepared ZnO and Co/ZnO nanohybrid.
3.3 Thermal properties
The Co/ZnO nanohybrid was further subjected to gravimetric (TGA) testing to ascertain the weight loss process and an approximate calcination temperature. The precipitate obtained was washed with deionized water followed by ethanol, and it was dried at 100°C. The TGA curve of Co/ZnO nanoparticles is shown in Figure 5. Under a nitrogen environment, the synthesized catalyst was heated at a rate of 10°C/min until it reached 1,000°C. This suggests an 8.7% weight decrease, which might be the result of ethanol evaporation. The two subsequent phases of the degradation were demonstrated to take place between 122–154°C and 200–400°C, respectively. The weight dropped by 3.4 and 28.7% in the second and third stages, respectively. The weight decrease in the second stage may be due to the evaporation of the water content. The temperatures between 122 and 154°C and 200 and 400°C were observed to constitute the second and third stages of the breakdown, respectively. The weight loss in the second step, however, is due to the disintegration of the Zn–Co precursor which results in the formation of the Co/ZnO nanohybrid. The calcination temperature of the powders was chosen to be above 400°C because there was no visible difference in the weight loss at that temperature.

Thermogram curve of the prepared Co/ZnO nanohybrid.
3.4 Surface area and bandgap energy
Figure 6 shows the results of BET analysis, which was used to determine the surface area of ZnO and Co-doped ZnO nanoparticles prepared by sol–gel combustion. At high relative pressures (P/P o), the non-limiting adsorption of the catalysts is characteristic of the H3 loop type, which indicates the presence of mesoporous and macroporous structures. As shown in Table 1, the BET surface area of the Co/ZnO nanohybrid is 84 m2/g, which is higher than that of pure ZnO (53 m2/g). This is due to the doping of cobalt into ZnO, which increases the number of active sites on the surface of the nanoparticles. The higher surface area of the Co/ZnO nanohybrid allows it to accommodate more dye molecules, which leads to a higher degradation rate.

Sorption isotherms of the prepared samples.
Properties of the prepared samples
| Sample name | Particle size (nm) | Crystalline size (nm) | Surface area (m2/g) | Bandgap energy (eV) |
|---|---|---|---|---|
| ZnO | 39 | 29.6 | 53 | 3.06 |
| Co/ZnO | 31 | 21.3 | 84 | 2.4 |
Figure 7 shows UV-visible diffuse reflectance spectra (DRS) of the prepared ZnO and Co/ZnO nanohybrid via the sol–gel approach supported by the combustion process. The optical properties (bandgap energy in eV) of the prepared samples were examined by using the Tauc plot:

UV-DRS spectral analysis of the prepared samples.
The analysis results indicate that the prepared nanohybrid (Co/ZnO) exhibits lower bandgap energy (2.4 eV) than the pure ZnO (3.06 eV), as presented in Table 1. The lower bandgap energy material shows greater photocatalytic performance towards the degradation of AR dye.
3.5 Photocatalytic degradation of the AR dye
Figure 8a shows the photocatalytic performance of the prepared Co/ZnO nanohybrid as a suitable photocatalyst for the decolourization of the AR dye under visible light irradiation. A lower photodegradation rate was observed when pure ZnO was used (48% in 200 min). As expected, the degradation rate was increased with the Co/ZnO nanohybrid at similar conditions. These results lead to further examination of optimized conditions for complete degradation of the AR dye under visible light irradiation. By changing the target parameter while keeping the other parameters constant, the effects of the reaction parameters such as pH, catalyst dose, and initial dye concentrations were examined to reach the maximum photodegradation rate of the AR dye.

(a) Degradation of the AR dye. Effect of (b) pH, (c) catalyst dose, and (d) initial dye concentration on the degradation of AR dye using the Co/ZnO nanohybrid.
3.5.1 Optimization conditions
Because of the effect of the electrostatic interactions between the catalyst surface (Co/ZnO), AR dye, and charged radicals, the pH of the solution is an important variable parameter in the evaluation of the photocatalytic dye degradation efficiency of the catalyst in an aqueous medium. Using the prepared Co/ZnO catalyst, the impact of pH on the percentage degradation of the AR dye when exposed to visible light was determined. The results are shown in Figure 8b. It can be seen from the figure that in acidic media as opposed to the basic medium, AR degrades at a higher proportion. The negatively charged dye molecules and the positively charged catalyst surface may interact more electrostatically as a result [26]. The catalyst surface develops a −ve charge and repels the same charged dye molecules electrostatically when the pH is increased to a basic medium. The rate of AR degradation was maximum at acidic pH 2. The negatively charged AR can easily adsorb on the catalyst surface.
Figure 8(c) shows the impact of the catalyst dosage on AR degradation. The rate of degradation was calculated by varying the catalyst concentrations (50, 100, 150, and 200 mg) applied to 100 mL of solution containing 10 ppm of dye at pH 2. The rate of degradation increases linearly up to a catalyst loading of 150 mg and then starts to decrease. The catalyst particles may not be activated by light transmission due to an increase in turbidity and agglomeration of the catalyst particles [27], and the catalyst particles may also be deactivated by collisions between active molecules and the ground state molecules of Co/ZnO [28]. The AR dye at different concentrations ranging from 5 to 30 ppm was used to evaluate the impact of the initial dye concentration (AR) at a fixed catalyst weight (150 mg) and pH 2. The rate of AR dye degradation increased up to 20 ppm, as shown in Figure 8(d). However, if the dye concentration is increased further, the catalyst will become inactive due to the blanket effect, and the rate of degradation decreases [29].
3.5.2 Recyclability and sustainability
The catalyst’s stability was evaluated by recycling tests that were exposed to visible light. After 120 min, the photocatalytic reaction with Co-doped ZnO was completed. The photocatalyst was then taken from the solution and rinsed with distilled water. The photocatalyst concentration and AR were both maintained constant. Figure 9a demonstrated that even after four cycles, the catalyst’s catalytic activity towards the pollutant was still substantial. It was observed that the high degree of repeatability of the photocatalytic activity may be due to the AR dye molecules coating the photocatalyst surface. The Co/ZnO nanocatalyst surface properties and photocatalytic performance are impacted by the extremely challenging nature of cleaning the synthesized catalyst surface. The combustion-supported sol–gel approach is fascinating for the better photocatalytic performance of the Co/ZnO nanohybrid over AR dye under visible light irradiation and stable for successive five runs without maximum loss as shown in Figure 9b. This is evident from the XRD patterns that are the same compared to that of the fresh ones.

Recyclability (a) and sustainability (b) of the Co/ZnO nanohybrid.
3.5.3 Possible mechanism
Based on the results of previous experiments [30], a simple and feasible mechanism for the oxidative photocatalytic degradation of AR dye under Co/ZnO nanohybrid illumination is provided (Figure 10). For this reason, ZnO was first exposed to photon energy from visible light, and then electrons moving to the conduction band (CB) and holes (h+) were produced in the valence band. Hydroxyl radicals (˙OH), which react with an aqueous solution, are formed when h+ interacts with it. Superoxide radicals (˙O2) are generated when the excited electron in CB interacts with oxygen molecules. Radicals, also known as reactive oxygen species, are mostly responsible for degrading the AR dye into non-biodegradable elements like water and carbon dioxide.

Possible mechanism for photocatalytic degradation of the AR dye.
3.5.4 Antibacterial performance
The prepared Co/ZnO nanohybrids were further examined for their antibacterial properties on S. pausimobilis and S. pyrogenes using the well diffusion method [30]. Various concentrations of Co/ZnO nanoparticles were placed in different wells of a Petri dish at standard concentrations of 200 µg/mL (1), 300 µg/mL (2), and 400 µg/mL (3) along with chloramphenicol as a positive control (4). Figure 11 shows the antibacterial performance of the prepared Co/ZnO nanohybrid. The diameter of the bacterial growth zone was calculated and is shown in Table 2. The results of the activity tests revealed that there is no activity observed in S. pyrogenes, but the optimal concentration of Co/ZnO for the zone of inhibition of S. pausimobilis (400 µg/mL) is also very nearer to the reference value; Co/ZnO nanoparticles have good antibacterial activity. The electron–hole formation that occurs in the valance band of ZnO after the catalyst is exposed to visible light may be the cause of this inhibition. This e−/h+, positive hole functions as a strong oxidizing agent under visible light, which could destroy the protein coat of the bacteria and inhibit its growth.
Antibacterial properties of Co/ZnO against (a) S. pausimobilis and (b) S. pyrogenes.
Agar-well diffusion of the Co-doped ZnO nanohybrid over S. pausimobilis and S. pyrogenes
| Organism | 200 µg/mL | 300 µg/mL | 400 µg/mL | Control µg/mL |
|---|---|---|---|---|
| S. pausimobilis | — | — | 16 mm | 23 mm |
| S. pyrogenes | — | — | — | 25 mm |
4 Conclusion
Cobalt-doped ZnO nanohybrids were synthesized by the combustion-supported sol–gel method at various concentrations. At 400°C, the synthesized nanoparticles were all annealed. The particle size grows as the concentration of cobalt dopant increases. The obtained Co/ZnO nanoparticles exhibit high photocatalytic performance over the degradation of AR dye when exposed to visible light. Photodegradation performs well at lower pH levels from the photodegradation experiment results. When visible light is introduced to the dye solution, the photodecolorization process accelerates within 120 min. The Co/ZnO nanohybrid was the most effective for S. pausimobilis. The experimental results conclude that Co/ZnO acts as a better photocatalyst for AR dye degradation under visible light irradiation and antibacterial performance. The prepared Co/ZnO nanohybrid showed an increase in photocatalytic activity upon illumination and acts as a benign catalyst for the degradation of AR dye and antimicrobial resistance for a few pathogens.
Acknowledgement
The authors express their gratitude to Bio Enviro Chemical Solutions, Visakhapatnam, for providing an instrumentation facility.
-
Funding information: No financial support.
-
Author contributions: Sattaru Gouthamsri and Malla Ramanaiah: Formal analysis, methodology, data interpretation, writing-original draft; Kommu Jaya Rao and Keloth Basavaiah: Writing-review & editing.
-
Conflict of interest: The authors declare that there were no conflicts of interest.
-
Ethical approval: The conducted research is not related to either human or animal use.
-
Data availability statement: The data will be provided by mail request to the corresponding author.
References
[1] Klingshirn C. ZnO: From basics towards applications. Phys Stat Sol. B. 2007;244:3027–73.10.1002/pssb.200743072Suche in Google Scholar
[2] Wong E, Searson P. ZnO quantum particle thin films fabricated by electrophoretic deposition. Appl Phys Lett. 1999;74:2939.10.1063/1.123972Suche in Google Scholar
[3] Vispute RD, Huuavarad SS, Pugel DE, Kulkami VN, Dhar S, Takeuchi I, et al. Wide band gap ZnO And ZnMgO heterostructures for future optoelectronic devices. In: Thin Films and Heterostructures for Oxide Electronics. Multifunctional Thin Film Series. Berlin Heidelberg New York: Springer; 2005. p. 301–30.10.1007/0-387-26089-7_10Suche in Google Scholar
[4] Wang XD, Zhou J, Song JH, Liu J, Xu N, Wang ZL. Piezoelectric field effect transistor and nanoforce sensor based on a single ZnO nanowire. Nano Lett. 2006;6:2768–72.10.1021/nl061802gSuche in Google Scholar PubMed
[5] Yang PD, Yan HQ, Mao S, Russo R, Johnson J, Saykally R, et al. Controlled growth of ZnO nanowires and their optical properties. Adv Funct Mater. 2002;12:323–31.10.1002/1616-3028(20020517)12:5<323::AID-ADFM323>3.0.CO;2-GSuche in Google Scholar
[6] Law M, Greene LE, Johnson JC, Saykally R, Yang PD. Nanowire dye-sensitized solar cells. Nat Mater. 2005;4:455–9.10.1038/nmat1387Suche in Google Scholar
[7] Navale SC, Gosavi SW, Mulla Talanta IS. Controlled synthesis of ZnO from nanospheres to micro-rods and its gas sensing studies. Talenta. 2008;75:1315–9.10.1016/j.talanta.2008.01.063Suche in Google Scholar
[8] Zhang J, Wang S, Wang Y, Xu M, Xia H, Zhang S, et al. ZnO hollow spheres: Preparation, characterization, and gas sensing properties. Sens Actuators B. 2009;139:411–7.10.1016/j.snb.2009.03.014Suche in Google Scholar
[9] Jin Z, Fukumura T, Kawasaki M, Ando K, Saito H, Sekiguchi T, et al. High throughput fabrication of transition-metal-doped epitaxial ZnO thin films: a series of oxide-diluted magnetic semiconductors and their properties. Appl Phys Lett. 2001;78:3824–6.10.1063/1.1377856Suche in Google Scholar
[10] Simimol A, Anappara AA, Barshilia HC. Influence of defects on electrical properties of electrodeposited co-doped ZnO nanocoatings. Mater Res Express. 2017;4:015001.10.1088/2053-1591/aa5135Suche in Google Scholar
[11] Simimol A, Anappara AA, Greulich-Weber S, Chowdhury P, Barshilia HC. Enhanced room temperature ferromagnetism in electrodeposited Co-doped ZnO nanostructured thin films by controlling the oxygen vacancy defects. J Appl Phys. 2015;117:214310.10.1063/1.4922050Suche in Google Scholar
[12] El Mir L, Ben Ayadi Z, Rahmouni H, El Ghoul J, Djessas K, von Bardeleben HJ. Elaboration and characterization of Co doped, conductive ZnO thin films deposited by radio-frequency magnetron sputtering at room temperature. Thin Solid Films. 2009;517:6007–11.10.1016/j.tsf.2009.03.197Suche in Google Scholar
[13] Ahmed F, Kumar S, Arshi N, Anwar MS, Koo BH, Lee CG. Doping effects of Co2+ ions on structural and magnetic properties of ZnO nanoparticles. Microelectron Eng. 2012; 89:129–32.10.1016/j.mee.2011.03.149Suche in Google Scholar
[14] Gu H, Zhang W, Xu Y, Yan M. Effect of oxygen deficiency on room temperature ferromagnetism in Co doped ZnO. Appl Phys Lett. 2012;100:202401.10.1063/1.4717741Suche in Google Scholar
[15] Pal B, Dhara S, Giri PK, Sarkar D. Room temperature ferromagnetism with high magnetic moment and optical properties of Co doped ZnO nanorods synthesized by a solvothermal route. J Alloy Compd. 2014;615:378–85.10.1016/j.jallcom.2014.06.087Suche in Google Scholar
[16] Al-Toriahi AKM, Azooz EA, Al-Mulla EAJ. Metal nanoparticles and nano-filters for the disposal of hospital waste: a review. Nano Biomed Eng. 2023;15(2):179–90.10.26599/NBE.2023.9290017Suche in Google Scholar
[17] Taddesse AM, Bekele T, Diaz I, Adgo A. Polyaniline supported CdS/CeO2/Ag3PO4 nanocomposite: An “A-B” type tandem n-n heterojunctions with enhanced photocatalytic activity. J Photochem Photobiol A: Chem. 2021;406:113005.10.1016/j.jphotochem.2020.113005Suche in Google Scholar
[18] Carvalho HB, Godoy MPF, Paes RWD, Mir M, Zevallos FAO, Iikawa MJSP, et al. Absence of ferromagnetic order in high quality bulk Co-doped ZnO samples. Appl Phys. 2010;108:033914–9.10.1063/1.3488970Suche in Google Scholar
[19] Kenawy E-R, Ghfar AA, Wabaidur SM, Khan MA, Siddiqui MR, Alothman ZA, et al. Cetyltrimethylammonium bromide intercalated and branched polyhydroxystyrene functionalized montmorillonite clay to sequester cationic dyes. J Environ Manag. 2018;219:285–93.Suche in Google Scholar
[20] Othman ZAA, Wabaidur SM. Application of carbon nanotubes in extraction and chromatographic analysis: a review. Arab J Chem. 2019;12(5):633–51.10.1016/j.arabjc.2018.05.012Suche in Google Scholar
[21] Kwon YJ, Kim KH, Lim CS, Shim KB. Characterization o fZnO nanopowders synthesized by the polymerized complex method via an organochemical route. J Ceram Proc Res. 2002;3:146–9.Suche in Google Scholar
[22] Lakshmi YK, Srinivas K, Sreedhar B, Raja MM, Vithald M, Reddy PV. Structural, optical, and magnetic properties of nanocrystalline Zn0.9Co0.1O-based diluted magnetic semiconductors. Mater Chem Phys. 2009;113:749–55.10.1016/j.matchemphys.2008.08.021Suche in Google Scholar
[23] Bouloudenine M, Viart N, Colis S, Dinia A. Bulk Zn1−xCoxO magnetic semiconductors prepared by hydrothermal technique. Chem Phys Lett. 2004;397:73–6.10.1016/j.cplett.2004.08.064Suche in Google Scholar
[24] Kenawy E-R, Ghfar AA, Wabaidur SM, Ali Khan MA, Raza Siddiqui MR, Alothman ZA, et al. Cetyltrimethylammonium bromide intercalated and branched polyhydroxystyrene functionalized montmorillonite clay to sequester cationic dyes. J Environ Manag. 2018;219:285–93.10.1016/j.jenvman.2018.04.121Suche in Google Scholar PubMed
[25] Liu H, Yang D, Sun H, Zhu Z. Microwave assisted hydro-thermal synthesis and characterization of hierarchical structured ZnO nanorods. J Optoelectron Adv Mater. 2010;12:2063–8.Suche in Google Scholar
[26] Rauf MA, Salman Ashraf S. Fundamental principles and application of heterogeneous photocatalytic degradation of dyes in solution. Chem Eng J. 2009;151:10–8.10.1016/j.cej.2009.02.026Suche in Google Scholar
[27] Chen CC. Degradation pathways of ethyl violet by photocatalytic reaction with ZnO dispersions. J Mol Catal A: Chem. 2007;264:82–92.10.1016/j.molcata.2006.09.013Suche in Google Scholar
[28] Kusvuran E, Gulnaz O, Irmak S, Atanur OM, Yavuz HI, Erbatur O. Comparison of several advanced oxidation processes for the decolourization of reactive red 120 azo dye in aqueous solution. J Hazard Mater B. 2004;109:85–93.10.1016/j.jhazmat.2004.03.009Suche in Google Scholar PubMed
[29] Divya Lakshmi KV, Siva Rao T, Swathi Padmaja J, Manga Raju I, Abdul Alim SK, Kalyani P. Visible light driven mesoporous Mn and S co-doped TiO2 nano material: characterization and applications in photocatalytic degradation of indigocarmine dye and antibacterial activity. Environ Nanotechnol Monit Manag. 2018;10:494–504.10.1016/j.enmm.2018.11.001Suche in Google Scholar
[30] Botsa SM, Kumar YP, Basavaiah K. Facile simultaneous synthesis of tetraaniline nanostructures/silver nanoparticles as heterogeneous catalyst for the efficient catalytic reduction of 4-nitrophenol to 4-aminophenol. RSC Adv. 2020;10(37):22043–53.10.1039/D0RA03327HSuche in Google Scholar PubMed PubMed Central
© 2023 the author(s), published by De Gruyter
This work is licensed under the Creative Commons Attribution 4.0 International License.
Artikel in diesem Heft
- Characteristics, source, and health risk assessment of aerosol polyaromatic hydrocarbons in the rural and urban regions of western Saudi Arabia
- Regular Articles
- A network-based correlation research between element electronegativity and node importance
- Pomegranate attenuates kidney injury in cyclosporine-induced nephrotoxicity in rats by suppressing oxidative stress
- Ab initio study of fundamental properties of XInO3 (X = K, Rb, Cs) perovskites
- Responses of feldspathic sandstone and sand-reconstituted soil C and N to freeze–thaw cycles
- Robust fractional control based on high gain observers design (RNFC) for a Spirulina maxima culture interfaced with an advanced oxidation process
- Study on arsenic speciation and redistribution mechanism in Lonicera japonica plants via synchrotron techniques
- Optimization of machining Nilo 36 superalloy parameters in turning operation
- Vacuum impregnation pre-treatment: A novel method for incorporating mono- and divalent cations into potato strips to reduce the acrylamide formation in French fries
- Characterization of effective constituents in Acanthopanax senticosus fruit for blood deficiency syndrome based on the chinmedomics strategy
- Comparative analysis of the metabolites in Pinellia ternata from two producing regions using ultra-high-performance liquid chromatography–electrospray ionization–tandem mass spectrometry
- The assessment of environmental parameter along the desalination plants in the Kingdom of Saudi Arabia
- Effects of harpin and carbendazim on antioxidant accumulation in young jujube leaves
- The effects of in ovo injected with sodium borate on hatching performance and small intestine morphology in broiler chicks
- Optimization of cutting forces and surface roughness via ANOVA and grey relational analysis in machining of In718
- Essential oils of Origanum compactum Benth: Chemical characterization, in vitro, in silico, antioxidant, and antibacterial activities
- Translocation of tungsten(vi) oxide/gadolinium(iii) fluoride in tellurite glasses towards improvement of gamma-ray attenuation features in high-density glass shields
- Mechanical properties, elastic moduli, and gamma ray attenuation competencies of some TeO2–WO3–GdF3 glasses: Tailoring WO3–GdF3 substitution toward optimum behavioral state range
- Comparison between the CIDR or sponge with hormone injection to induce estrus synchronization for twining and sex preselection in Naimi sheep
- Exergetic performance analyses of three different cogeneration plants
- Psoralea corylifolia (babchi) seeds enhance proliferation of normal human cultured melanocytes: GC–MS profiling and biological investigation
- A novel electrochemical micro-titration method for quantitative evaluation of the DPPH free radical scavenging capacity of caffeic acid
- Comparative study between supported bimetallic catalysts for nitrate remediation in water
- Persicaline, an alkaloid from Salvadora persica, inhibits proliferation and induces apoptosis and cell-cycle arrest in MCF-7 cells
- Determination of nicotine content in locally produced smokeless tobacco (Shammah) samples from Jazan region of Saudi Arabia using a convenient HPLC-MS/MS method
- Changes in oxidative stress markers in pediatric burn injury over a 1-week period
- Integrated geophysical techniques applied for petroleum basins structural characterization in the central part of the Western Desert, Egypt
- The impact of chemical modifications on gamma-ray attenuation properties of some WO3-reinforced tellurite glasses
- Microwave and Cs+-assisted chemo selective reaction protocol for synthesizing 2-styryl quinoline biorelevant molecules
- Structural, physical, and radiation absorption properties of a significant nuclear power plant component: A comparison between REX-734 and 316L SS austenitic stainless steels
- Effect of Moringa oleifera on serum YKL-40 level: In vivo rat periodontitis model
- Investigating the impact of CO2 emissions on the COVID-19 pandemic by generalized linear mixed model approach with inverse Gaussian and gamma distributions
- Influence of WO3 content on gamma rays attenuation characteristics of phosphate glasses at low energy range
- Study on CO2 absorption performance of ternary DES formed based on DEA as promoting factor
- Performance analyses of detonation engine cogeneration cycles
- Sterols from Centaurea pumilio L. with cell proliferative activity: In vitro and in silico studies
- Untargeted metabolomics revealing changes in aroma substances in flue-cured tobacco
- Effect of pumpkin enriched with calcium lactate on iron status in an animal model of postmenopausal osteoporosis
- Energy consumption, mechanical and metallographic properties of cryogenically treated tool steels
- Optimization of ultra-high pressure-assisted extraction of total phenols from Eucommia ulmoides leaves by response surface methodology
- Harpin enhances antioxidant nutrient accumulation and decreases enzymatic browning in stored soybean sprouts
- Physicochemical and biological properties of carvacrol
- Radix puerariae in the treatment of diabetic nephropathy: A network pharmacology analysis and experimental validation
- Anti-Alzheimer, antioxidants, glucose-6-phosphate dehydrogenase effects of Taverniera glabra mediated ZnO and Fe2O3 nanoparticles in alloxan-induced diabetic rats
- Experimental study on photocatalytic CO2 reduction performance of ZnS/CdS-TiO2 nanotube array thin films
- Epoxy-reinforced heavy metal oxides for gamma ray shielding purposes
- Black mulberry (Morus nigra L.) fruits: As a medicinal plant rich in human health-promoting compounds
- Promising antioxidant and antimicrobial effects of essential oils extracted from fruits of Juniperus thurifera: In vitro and in silico investigations
- Chloramine-T-induced oxidation of Rizatriptan Benzoate: An integral chemical and spectroscopic study of products, mechanisms and kinetics
- Study on antioxidant and antimicrobial potential of chemically profiled essential oils extracted from Juniperus phoenicea (L.) by use of in vitro and in silico approaches
- Screening and characterization of fungal taxol-producing endophytic fungi for evaluation of antimicrobial and anticancer activities
- Mineral composition, principal polyphenolic components, and evaluation of the anti-inflammatory, analgesic, and antioxidant properties of Cytisus villosus Pourr leaf extracts
- In vitro antiproliferative efficacy of Annona muricata seed and fruit extracts on several cancer cell lines
- An experimental study for chemical characterization of artificial anterior cruciate ligament with coated chitosan as biomaterial
- Prevalence of residual risks of the transfusion-transmitted infections in Riyadh hospitals: A two-year retrospective study
- Computational and experimental investigation of antibacterial and antifungal properties of Nicotiana tabacum extracts
- Reinforcement of cementitious mortars with hemp fibers and shives
- X-ray shielding properties of bismuth-borate glass doped with rare earth ions
- Green supported silver nanoparticles over modified reduced graphene oxide: Investigation of its antioxidant and anti-ovarian cancer effects
- Orthogonal synthesis of a versatile building block for dual functionalization of targeting vectors
- Thymbra spicata leaf extract driven biogenic synthesis of Au/Fe3O4 nanocomposite and its bio-application in the treatment of different types of leukemia
- The role of Ag2O incorporation in nuclear radiation shielding behaviors of the Li2O–Pb3O4–SiO2 glass system: A multi-step characterization study
- A stimuli-responsive in situ spray hydrogel co-loaded with naringenin and gentamicin for chronic wounds
- Assessment of the impact of γ-irradiation on the piperine content and microbial quality of black pepper
- Antioxidant, sensory, and functional properties of low-alcoholic IPA beer with Pinus sylvestris L. shoots addition fermented using unconventional yeast
- Screening and optimization of extracellular pectinase produced by Bacillus thuringiensis SH7
- Determination of polyphenols in Chinese jujube using ultra-performance liquid chromatography–mass spectrometry
- Synergistic effects of harpin and NaCl in determining soybean sprout quality under non-sterile conditions
- Field evaluation of different eco-friendly alternative control methods against Panonychus citri [Acari: Tetranychidae] spider mite and its predators in citrus orchards
- Exploring the antimicrobial potential of biologically synthesized zero valent iron nanoparticles
- NaCl regulates goldfish growth and survival at three food supply levels under hypoxia
- An exploration of the physical, optical, mechanical, and radiation shielding properties of PbO–MgO–ZnO–B2O3 glasses
- A novel statistical modeling of air pollution and the COVID-19 pandemic mortality data by Poisson, geometric, and negative binomial regression models with fixed and random effects
- Treatment activity of the injectable hydrogels loaded with dexamethasone In(iii) complex on glioma by inhibiting the VEGF signaling pathway
- An alternative approach for the excess lifetime cancer risk and prediction of radiological parameters
- Panax ginseng leaf aqueous extract mediated green synthesis of AgNPs under ultrasound condition and investigation of its anti-lung adenocarcinoma effects
- Study of hydrolysis and production of instant ginger (Zingiber officinale) tea
- Novel green synthesis of zinc oxide nanoparticles using Salvia rosmarinus extract for treatment of human lung cancer
- Evaluation of second trimester plasma lipoxin A4, VEGFR-1, IL-6, and TNF-α levels in pregnant women with gestational diabetes mellitus
- Antidiabetic, antioxidant and cytotoxicity activities of ortho- and para-substituted Schiff bases derived from metformin hydrochloride: Validation by molecular docking and in silico ADME studies
- Antioxidant, antidiabetic, antiglaucoma, and anticholinergic effects of Tayfi grape (Vitis vinifera): A phytochemical screening by LC-MS/MS analysis
- Identification of genetic polymorphisms in the stearoyl CoA desaturase gene and its association with milk quality traits in Najdi sheep
- Cold-acclimation effect on cadmium absorption and biosynthesis of polyphenolics, and free proline and photosynthetic pigments in Spirogyra aequinoctialis
- Analysis of secondary metabolites in Xinjiang Morus nigra leaves using different extraction methods with UPLC-Q/TOF-MS/MS technology
- Nanoarchitectonics and performance evaluation of a Fe3O4-stabilized Pickering emulsion-type differential pressure plugging agent
- Investigating pyrolysis characteristics of Shengdong coal through Py-GC/MS
- Extraction, phytochemical characterization, and antifungal activity of Salvia rosmarinus extract
- Introducing a novel and natural antibiotic for the treatment of oral pathogens: Abelmoschus esculentus green-formulated silver nanoparticles
- Optimization of gallic acid-enriched ultrasonic-assisted extraction from mango peels
- Effect of gamma rays irradiation in the structure, optical, and electrical properties of samarium doped bismuth titanate ceramics
- Combinatory in silico investigation for potential inhibitors from Curcuma sahuynhensis Škorničk. & N.S. Lý volatile phytoconstituents against influenza A hemagglutinin, SARS-CoV-2 main protease, and Omicron-variant spike protein
- Physical, mechanical, and gamma ray shielding properties of the Bi2O3–BaO–B2O3–ZnO–As2O3–MgO–Na2O glass system
- Twofold interpenetrated 3D Cd(ii) complex: Crystal structure and luminescent property
- Study on the microstructure and soil quality variation of composite soil with soft rock and sand
- Ancient spring waters still emerging and accessible in the Roman Forum area: Chemical–physical and microbiological characterization
- Extraction and characterization of type I collagen from scales of Mexican Biajaiba fish
- Finding small molecular compounds to decrease trimethylamine oxide levels in atherosclerosis by virtual screening
- Prefatory in silico studies and in vitro insecticidal effect of Nigella sativa (L.) essential oil and its active compound (carvacrol) against the Callosobruchus maculatus adults (Fab), a major pest of chickpea
- Polymerized methyl imidazole silver bromide (CH3C6H5AgBr)6: Synthesis, crystal structures, and catalytic activity
- Using calcined waste fish bones as a green solid catalyst for biodiesel production from date seed oil
- Influence of the addition of WO3 on TeO2–Na2O glass systems in view of the feature of mechanical, optical, and photon attenuation
- Naringin ameliorates 5-fluorouracil elicited neurotoxicity by curtailing oxidative stress and iNOS/NF-ĸB/caspase-3 pathway
- GC-MS profile of extracts of an endophytic fungus Alternaria and evaluation of its anticancer and antibacterial potentialities
- Green synthesis, chemical characterization, and antioxidant and anti-colorectal cancer effects of vanadium nanoparticles
- Determination of caffeine content in coffee drinks prepared in some coffee shops in the local market in Jeddah City, Saudi Arabia
- A new 3D supramolecular Cu(ii) framework: Crystal structure and photocatalytic characteristics
- Bordeaux mixture accelerates ripening, delays senescence, and promotes metabolite accumulation in jujube fruit
- Important application value of injectable hydrogels loaded with omeprazole Schiff base complex in the treatment of pancreatitis
- Color tunable benzothiadiazole-based small molecules for lightening applications
- Investigation of structural, dielectric, impedance, and mechanical properties of hydroxyapatite-modified barium titanate composites for biomedical applications
- Metal gel particles loaded with epidermal cell growth factor promote skin wound repair mechanism by regulating miRNA
- In vitro exploration of Hypsizygus ulmarius (Bull.) mushroom fruiting bodies: Potential antidiabetic and anti-inflammatory agent
- Alteration in the molecular structure of the adenine base exposed to gamma irradiation: An ESR study
- Comprehensive study of optical, thermal, and gamma-ray shielding properties of Bi2O3–ZnO–PbO–B2O3 glasses
- Lewis acids as co-catalysts in Pd-based catalyzed systems of the octene-1 hydroethoxycarbonylation reaction
- Synthesis, Hirshfeld surface analysis, thermal, and selective α-glucosidase inhibitory studies of Schiff base transition metal complexes
- Protective properties of AgNPs green-synthesized by Abelmoschus esculentus on retinal damage on the virtue of its anti-inflammatory and antioxidant effects in diabetic rat
- Effects of green decorated AgNPs on lignin-modified magnetic nanoparticles mediated by Cydonia on cecal ligation and puncture-induced sepsis
- Treatment of gastric cancer by green mediated silver nanoparticles using Pistacia atlantica bark aqueous extract
- Preparation of newly developed porcelain ceramics containing WO3 nanoparticles for radiation shielding applications
- Utilization of computational methods for the identification of new natural inhibitors of human neutrophil elastase in inflammation therapy
- Some anticancer agents as effective glutathione S-transferase (GST) inhibitors
- Clay-based bricks’ rich illite mineral for gamma-ray shielding applications: An experimental evaluation of the effect of pressure rates on gamma-ray attenuation parameters
- Stability kinetics of orevactaene pigments produced by Epicoccum nigrum in solid-state fermentation
- Treatment of denture stomatitis using iron nanoparticles green-synthesized by Silybum marianum extract
- Characterization and antioxidant potential of white mustard (Brassica hirta) leaf extract and stabilization of sunflower oil
- Characteristics of Langmuir monomolecular monolayers formed by the novel oil blends
- Strategies for optimizing the single GdSrFeO4 phase synthesis
- Oleic acid and linoleic acid nanosomes boost immunity and provoke cell death via the upregulation of beta-defensin-4 at genetic and epigenetic levels
- Unraveling the therapeutic potential of Bombax ceiba roots: A comprehensive study of chemical composition, heavy metal content, antibacterial activity, and in silico analysis
- Green synthesis of AgNPs using plant extract and investigation of its anti-human colorectal cancer application
- The adsorption of naproxen on adsorbents obtained from pepper stalk extract by green synthesis
- Treatment of gastric cancer by silver nanoparticles encapsulated by chitosan polymers mediated by Pistacia atlantica extract under ultrasound condition
- In vitro protective and anti-inflammatory effects of Capparis spinosa and its flavonoids profile
- Wear and corrosion behavior of TiC and WC coatings deposited on high-speed steels by electro-spark deposition
- Therapeutic effects of green-formulated gold nanoparticles by Origanum majorana on spinal cord injury in rats
- Melanin antibacterial activity of two new strains, SN1 and SN2, of Exophiala phaeomuriformis against five human pathogens
- Evaluation of the analgesic and anesthetic properties of silver nanoparticles supported over biodegradable acacia gum-modified magnetic nanoparticles
- Review Articles
- Role and mechanism of fruit waste polyphenols in diabetes management
- A comprehensive review of non-alkaloidal metabolites from the subfamily Amaryllidoideae (Amaryllidaceae)
- Discovery of the chemical constituents, structural characteristics, and pharmacological functions of Chinese caterpillar fungus
- Eco-friendly green approach of nickel oxide nanoparticles for biomedical applications
- Advances in the pharmaceutical research of curcumin for oral administration
- Rapid Communication
- Determination of the contents of bioactive compounds in St. John’s wort (Hypericum perforatum): Comparison of commercial and wild samples
- Retraction
- Retraction of “Two mixed-ligand coordination polymers based on 2,5-thiophenedicarboxylic acid and flexible N-donor ligands: The protective effect on periodontitis via reducing the release of IL-1β and TNF-α”
- Topical Issue on Phytochemicals, biological and toxicological analysis of aromatic medicinal plants
- Anti-plasmodial potential of selected medicinal plants and a compound Atropine isolated from Eucalyptus obliqua
- Anthocyanin extract from black rice attenuates chronic inflammation in DSS-induced colitis mouse model by modulating the gut microbiota
- Evaluation of antibiofilm and cytotoxicity effect of Rumex vesicarius methanol extract
- Chemical compositions of Litsea umbellata and inhibition activities
- Green synthesis, characterization of silver nanoparticles using Rhynchosia capitata leaf extract and their biological activities
- GC-MS analysis and antibacterial activities of some plants belonging to the genus Euphorbia on selected bacterial isolates
- The abrogative effect of propolis on acrylamide-induced toxicity in male albino rats: Histological study
- A phytoconstituent 6-aminoflavone ameliorates lipopolysaccharide-induced oxidative stress mediated synapse and memory dysfunction via p-Akt/NF-kB pathway in albino mice
- Anti-diabetic potentials of Sorbaria tomentosa Lindl. Rehder: Phytochemistry (GC-MS analysis), α-amylase, α-glucosidase inhibitory, in vivo hypoglycemic, and biochemical analysis
- Assessment of cytotoxic and apoptotic activities of the Cassia angustifolia aqueous extract against SW480 colon cancer
- Biochemical analysis, antioxidant, and antibacterial efficacy of the bee propolis extract (Hymenoptera: Apis mellifera) against Staphylococcus aureus-induced infection in BALB/c mice: In vitro and in vivo study
- Assessment of essential elements and heavy metals in Saudi Arabian rice samples underwent various processing methods
- Two new compounds from leaves of Capparis dongvanensis (Sy, B. H. Quang & D. V. Hai) and inhibition activities
- Hydroxyquinoline sulfanilamide ameliorates STZ-induced hyperglycemia-mediated amyleoid beta burden and memory impairment in adult mice
- An automated reading of semi-quantitative hemagglutination results in microplates: Micro-assay for plant lectins
- Inductively coupled plasma mass spectrometry assessment of essential and toxic trace elements in traditional spices consumed by the population of the Middle Eastern region in their recipes
- Phytochemical analysis and anticancer activity of the Pithecellobium dulce seed extract in colorectal cancer cells
- Impact of climatic disturbances on the chemical compositions and metabolites of Salvia officinalis
- Physicochemical characterization, antioxidant and antifungal activities of essential oils of Urginea maritima and Allium sativum
- Phytochemical analysis and antifungal efficiency of Origanum majorana extracts against some phytopathogenic fungi causing tomato damping-off diseases
- Special Issue on 4th IC3PE
- Graphene quantum dots: A comprehensive overview
- Studies on the intercalation of calcium–aluminium layered double hydroxide-MCPA and its controlled release mechanism as a potential green herbicide
- Synergetic effect of adsorption and photocatalysis by zinc ferrite-anchored graphitic carbon nitride nanosheet for the removal of ciprofloxacin under visible light irradiation
- Exploring anticancer activity of the Indonesian guava leaf (Psidium guajava L.) fraction on various human cancer cell lines in an in vitro cell-based approach
- The comparison of gold extraction methods from the rock using thiourea and thiosulfate
- Special Issue on Marine environmental sciences and significance of the multidisciplinary approaches
- Sorption of alkylphenols and estrogens on microplastics in marine conditions
- Cytotoxic ketosteroids from the Red Sea soft coral Dendronephthya sp.
- Antibacterial and biofilm prevention metabolites from Acanthophora spicifera
- Characteristics, source, and health risk assessment of aerosol polyaromatic hydrocarbons in the rural and urban regions of western Saudi Arabia
- Special Issue on Advanced Nanomaterials for Energy, Environmental and Biological Applications - Part II
- Green synthesis, characterization, and evaluation of antibacterial activities of cobalt nanoparticles produced by marine fungal species Periconia prolifica
- Combustion-mediated sol–gel preparation of cobalt-doped ZnO nanohybrids for the degradation of acid red and antibacterial performance
- Perinatal supplementation with selenium nanoparticles modified with ascorbic acid improves hepatotoxicity in rat gestational diabetes
- Evaluation and chemical characterization of bioactive secondary metabolites from endophytic fungi associated with the ethnomedicinal plant Bergenia ciliata
- Enhancing photovoltaic efficiency with SQI-Br and SQI-I sensitizers: A comparative analysis
- Nanostructured p-PbS/p-CuO sulfide/oxide bilayer heterojunction as a promising photoelectrode for hydrogen gas generation
Artikel in diesem Heft
- Characteristics, source, and health risk assessment of aerosol polyaromatic hydrocarbons in the rural and urban regions of western Saudi Arabia
- Regular Articles
- A network-based correlation research between element electronegativity and node importance
- Pomegranate attenuates kidney injury in cyclosporine-induced nephrotoxicity in rats by suppressing oxidative stress
- Ab initio study of fundamental properties of XInO3 (X = K, Rb, Cs) perovskites
- Responses of feldspathic sandstone and sand-reconstituted soil C and N to freeze–thaw cycles
- Robust fractional control based on high gain observers design (RNFC) for a Spirulina maxima culture interfaced with an advanced oxidation process
- Study on arsenic speciation and redistribution mechanism in Lonicera japonica plants via synchrotron techniques
- Optimization of machining Nilo 36 superalloy parameters in turning operation
- Vacuum impregnation pre-treatment: A novel method for incorporating mono- and divalent cations into potato strips to reduce the acrylamide formation in French fries
- Characterization of effective constituents in Acanthopanax senticosus fruit for blood deficiency syndrome based on the chinmedomics strategy
- Comparative analysis of the metabolites in Pinellia ternata from two producing regions using ultra-high-performance liquid chromatography–electrospray ionization–tandem mass spectrometry
- The assessment of environmental parameter along the desalination plants in the Kingdom of Saudi Arabia
- Effects of harpin and carbendazim on antioxidant accumulation in young jujube leaves
- The effects of in ovo injected with sodium borate on hatching performance and small intestine morphology in broiler chicks
- Optimization of cutting forces and surface roughness via ANOVA and grey relational analysis in machining of In718
- Essential oils of Origanum compactum Benth: Chemical characterization, in vitro, in silico, antioxidant, and antibacterial activities
- Translocation of tungsten(vi) oxide/gadolinium(iii) fluoride in tellurite glasses towards improvement of gamma-ray attenuation features in high-density glass shields
- Mechanical properties, elastic moduli, and gamma ray attenuation competencies of some TeO2–WO3–GdF3 glasses: Tailoring WO3–GdF3 substitution toward optimum behavioral state range
- Comparison between the CIDR or sponge with hormone injection to induce estrus synchronization for twining and sex preselection in Naimi sheep
- Exergetic performance analyses of three different cogeneration plants
- Psoralea corylifolia (babchi) seeds enhance proliferation of normal human cultured melanocytes: GC–MS profiling and biological investigation
- A novel electrochemical micro-titration method for quantitative evaluation of the DPPH free radical scavenging capacity of caffeic acid
- Comparative study between supported bimetallic catalysts for nitrate remediation in water
- Persicaline, an alkaloid from Salvadora persica, inhibits proliferation and induces apoptosis and cell-cycle arrest in MCF-7 cells
- Determination of nicotine content in locally produced smokeless tobacco (Shammah) samples from Jazan region of Saudi Arabia using a convenient HPLC-MS/MS method
- Changes in oxidative stress markers in pediatric burn injury over a 1-week period
- Integrated geophysical techniques applied for petroleum basins structural characterization in the central part of the Western Desert, Egypt
- The impact of chemical modifications on gamma-ray attenuation properties of some WO3-reinforced tellurite glasses
- Microwave and Cs+-assisted chemo selective reaction protocol for synthesizing 2-styryl quinoline biorelevant molecules
- Structural, physical, and radiation absorption properties of a significant nuclear power plant component: A comparison between REX-734 and 316L SS austenitic stainless steels
- Effect of Moringa oleifera on serum YKL-40 level: In vivo rat periodontitis model
- Investigating the impact of CO2 emissions on the COVID-19 pandemic by generalized linear mixed model approach with inverse Gaussian and gamma distributions
- Influence of WO3 content on gamma rays attenuation characteristics of phosphate glasses at low energy range
- Study on CO2 absorption performance of ternary DES formed based on DEA as promoting factor
- Performance analyses of detonation engine cogeneration cycles
- Sterols from Centaurea pumilio L. with cell proliferative activity: In vitro and in silico studies
- Untargeted metabolomics revealing changes in aroma substances in flue-cured tobacco
- Effect of pumpkin enriched with calcium lactate on iron status in an animal model of postmenopausal osteoporosis
- Energy consumption, mechanical and metallographic properties of cryogenically treated tool steels
- Optimization of ultra-high pressure-assisted extraction of total phenols from Eucommia ulmoides leaves by response surface methodology
- Harpin enhances antioxidant nutrient accumulation and decreases enzymatic browning in stored soybean sprouts
- Physicochemical and biological properties of carvacrol
- Radix puerariae in the treatment of diabetic nephropathy: A network pharmacology analysis and experimental validation
- Anti-Alzheimer, antioxidants, glucose-6-phosphate dehydrogenase effects of Taverniera glabra mediated ZnO and Fe2O3 nanoparticles in alloxan-induced diabetic rats
- Experimental study on photocatalytic CO2 reduction performance of ZnS/CdS-TiO2 nanotube array thin films
- Epoxy-reinforced heavy metal oxides for gamma ray shielding purposes
- Black mulberry (Morus nigra L.) fruits: As a medicinal plant rich in human health-promoting compounds
- Promising antioxidant and antimicrobial effects of essential oils extracted from fruits of Juniperus thurifera: In vitro and in silico investigations
- Chloramine-T-induced oxidation of Rizatriptan Benzoate: An integral chemical and spectroscopic study of products, mechanisms and kinetics
- Study on antioxidant and antimicrobial potential of chemically profiled essential oils extracted from Juniperus phoenicea (L.) by use of in vitro and in silico approaches
- Screening and characterization of fungal taxol-producing endophytic fungi for evaluation of antimicrobial and anticancer activities
- Mineral composition, principal polyphenolic components, and evaluation of the anti-inflammatory, analgesic, and antioxidant properties of Cytisus villosus Pourr leaf extracts
- In vitro antiproliferative efficacy of Annona muricata seed and fruit extracts on several cancer cell lines
- An experimental study for chemical characterization of artificial anterior cruciate ligament with coated chitosan as biomaterial
- Prevalence of residual risks of the transfusion-transmitted infections in Riyadh hospitals: A two-year retrospective study
- Computational and experimental investigation of antibacterial and antifungal properties of Nicotiana tabacum extracts
- Reinforcement of cementitious mortars with hemp fibers and shives
- X-ray shielding properties of bismuth-borate glass doped with rare earth ions
- Green supported silver nanoparticles over modified reduced graphene oxide: Investigation of its antioxidant and anti-ovarian cancer effects
- Orthogonal synthesis of a versatile building block for dual functionalization of targeting vectors
- Thymbra spicata leaf extract driven biogenic synthesis of Au/Fe3O4 nanocomposite and its bio-application in the treatment of different types of leukemia
- The role of Ag2O incorporation in nuclear radiation shielding behaviors of the Li2O–Pb3O4–SiO2 glass system: A multi-step characterization study
- A stimuli-responsive in situ spray hydrogel co-loaded with naringenin and gentamicin for chronic wounds
- Assessment of the impact of γ-irradiation on the piperine content and microbial quality of black pepper
- Antioxidant, sensory, and functional properties of low-alcoholic IPA beer with Pinus sylvestris L. shoots addition fermented using unconventional yeast
- Screening and optimization of extracellular pectinase produced by Bacillus thuringiensis SH7
- Determination of polyphenols in Chinese jujube using ultra-performance liquid chromatography–mass spectrometry
- Synergistic effects of harpin and NaCl in determining soybean sprout quality under non-sterile conditions
- Field evaluation of different eco-friendly alternative control methods against Panonychus citri [Acari: Tetranychidae] spider mite and its predators in citrus orchards
- Exploring the antimicrobial potential of biologically synthesized zero valent iron nanoparticles
- NaCl regulates goldfish growth and survival at three food supply levels under hypoxia
- An exploration of the physical, optical, mechanical, and radiation shielding properties of PbO–MgO–ZnO–B2O3 glasses
- A novel statistical modeling of air pollution and the COVID-19 pandemic mortality data by Poisson, geometric, and negative binomial regression models with fixed and random effects
- Treatment activity of the injectable hydrogels loaded with dexamethasone In(iii) complex on glioma by inhibiting the VEGF signaling pathway
- An alternative approach for the excess lifetime cancer risk and prediction of radiological parameters
- Panax ginseng leaf aqueous extract mediated green synthesis of AgNPs under ultrasound condition and investigation of its anti-lung adenocarcinoma effects
- Study of hydrolysis and production of instant ginger (Zingiber officinale) tea
- Novel green synthesis of zinc oxide nanoparticles using Salvia rosmarinus extract for treatment of human lung cancer
- Evaluation of second trimester plasma lipoxin A4, VEGFR-1, IL-6, and TNF-α levels in pregnant women with gestational diabetes mellitus
- Antidiabetic, antioxidant and cytotoxicity activities of ortho- and para-substituted Schiff bases derived from metformin hydrochloride: Validation by molecular docking and in silico ADME studies
- Antioxidant, antidiabetic, antiglaucoma, and anticholinergic effects of Tayfi grape (Vitis vinifera): A phytochemical screening by LC-MS/MS analysis
- Identification of genetic polymorphisms in the stearoyl CoA desaturase gene and its association with milk quality traits in Najdi sheep
- Cold-acclimation effect on cadmium absorption and biosynthesis of polyphenolics, and free proline and photosynthetic pigments in Spirogyra aequinoctialis
- Analysis of secondary metabolites in Xinjiang Morus nigra leaves using different extraction methods with UPLC-Q/TOF-MS/MS technology
- Nanoarchitectonics and performance evaluation of a Fe3O4-stabilized Pickering emulsion-type differential pressure plugging agent
- Investigating pyrolysis characteristics of Shengdong coal through Py-GC/MS
- Extraction, phytochemical characterization, and antifungal activity of Salvia rosmarinus extract
- Introducing a novel and natural antibiotic for the treatment of oral pathogens: Abelmoschus esculentus green-formulated silver nanoparticles
- Optimization of gallic acid-enriched ultrasonic-assisted extraction from mango peels
- Effect of gamma rays irradiation in the structure, optical, and electrical properties of samarium doped bismuth titanate ceramics
- Combinatory in silico investigation for potential inhibitors from Curcuma sahuynhensis Škorničk. & N.S. Lý volatile phytoconstituents against influenza A hemagglutinin, SARS-CoV-2 main protease, and Omicron-variant spike protein
- Physical, mechanical, and gamma ray shielding properties of the Bi2O3–BaO–B2O3–ZnO–As2O3–MgO–Na2O glass system
- Twofold interpenetrated 3D Cd(ii) complex: Crystal structure and luminescent property
- Study on the microstructure and soil quality variation of composite soil with soft rock and sand
- Ancient spring waters still emerging and accessible in the Roman Forum area: Chemical–physical and microbiological characterization
- Extraction and characterization of type I collagen from scales of Mexican Biajaiba fish
- Finding small molecular compounds to decrease trimethylamine oxide levels in atherosclerosis by virtual screening
- Prefatory in silico studies and in vitro insecticidal effect of Nigella sativa (L.) essential oil and its active compound (carvacrol) against the Callosobruchus maculatus adults (Fab), a major pest of chickpea
- Polymerized methyl imidazole silver bromide (CH3C6H5AgBr)6: Synthesis, crystal structures, and catalytic activity
- Using calcined waste fish bones as a green solid catalyst for biodiesel production from date seed oil
- Influence of the addition of WO3 on TeO2–Na2O glass systems in view of the feature of mechanical, optical, and photon attenuation
- Naringin ameliorates 5-fluorouracil elicited neurotoxicity by curtailing oxidative stress and iNOS/NF-ĸB/caspase-3 pathway
- GC-MS profile of extracts of an endophytic fungus Alternaria and evaluation of its anticancer and antibacterial potentialities
- Green synthesis, chemical characterization, and antioxidant and anti-colorectal cancer effects of vanadium nanoparticles
- Determination of caffeine content in coffee drinks prepared in some coffee shops in the local market in Jeddah City, Saudi Arabia
- A new 3D supramolecular Cu(ii) framework: Crystal structure and photocatalytic characteristics
- Bordeaux mixture accelerates ripening, delays senescence, and promotes metabolite accumulation in jujube fruit
- Important application value of injectable hydrogels loaded with omeprazole Schiff base complex in the treatment of pancreatitis
- Color tunable benzothiadiazole-based small molecules for lightening applications
- Investigation of structural, dielectric, impedance, and mechanical properties of hydroxyapatite-modified barium titanate composites for biomedical applications
- Metal gel particles loaded with epidermal cell growth factor promote skin wound repair mechanism by regulating miRNA
- In vitro exploration of Hypsizygus ulmarius (Bull.) mushroom fruiting bodies: Potential antidiabetic and anti-inflammatory agent
- Alteration in the molecular structure of the adenine base exposed to gamma irradiation: An ESR study
- Comprehensive study of optical, thermal, and gamma-ray shielding properties of Bi2O3–ZnO–PbO–B2O3 glasses
- Lewis acids as co-catalysts in Pd-based catalyzed systems of the octene-1 hydroethoxycarbonylation reaction
- Synthesis, Hirshfeld surface analysis, thermal, and selective α-glucosidase inhibitory studies of Schiff base transition metal complexes
- Protective properties of AgNPs green-synthesized by Abelmoschus esculentus on retinal damage on the virtue of its anti-inflammatory and antioxidant effects in diabetic rat
- Effects of green decorated AgNPs on lignin-modified magnetic nanoparticles mediated by Cydonia on cecal ligation and puncture-induced sepsis
- Treatment of gastric cancer by green mediated silver nanoparticles using Pistacia atlantica bark aqueous extract
- Preparation of newly developed porcelain ceramics containing WO3 nanoparticles for radiation shielding applications
- Utilization of computational methods for the identification of new natural inhibitors of human neutrophil elastase in inflammation therapy
- Some anticancer agents as effective glutathione S-transferase (GST) inhibitors
- Clay-based bricks’ rich illite mineral for gamma-ray shielding applications: An experimental evaluation of the effect of pressure rates on gamma-ray attenuation parameters
- Stability kinetics of orevactaene pigments produced by Epicoccum nigrum in solid-state fermentation
- Treatment of denture stomatitis using iron nanoparticles green-synthesized by Silybum marianum extract
- Characterization and antioxidant potential of white mustard (Brassica hirta) leaf extract and stabilization of sunflower oil
- Characteristics of Langmuir monomolecular monolayers formed by the novel oil blends
- Strategies for optimizing the single GdSrFeO4 phase synthesis
- Oleic acid and linoleic acid nanosomes boost immunity and provoke cell death via the upregulation of beta-defensin-4 at genetic and epigenetic levels
- Unraveling the therapeutic potential of Bombax ceiba roots: A comprehensive study of chemical composition, heavy metal content, antibacterial activity, and in silico analysis
- Green synthesis of AgNPs using plant extract and investigation of its anti-human colorectal cancer application
- The adsorption of naproxen on adsorbents obtained from pepper stalk extract by green synthesis
- Treatment of gastric cancer by silver nanoparticles encapsulated by chitosan polymers mediated by Pistacia atlantica extract under ultrasound condition
- In vitro protective and anti-inflammatory effects of Capparis spinosa and its flavonoids profile
- Wear and corrosion behavior of TiC and WC coatings deposited on high-speed steels by electro-spark deposition
- Therapeutic effects of green-formulated gold nanoparticles by Origanum majorana on spinal cord injury in rats
- Melanin antibacterial activity of two new strains, SN1 and SN2, of Exophiala phaeomuriformis against five human pathogens
- Evaluation of the analgesic and anesthetic properties of silver nanoparticles supported over biodegradable acacia gum-modified magnetic nanoparticles
- Review Articles
- Role and mechanism of fruit waste polyphenols in diabetes management
- A comprehensive review of non-alkaloidal metabolites from the subfamily Amaryllidoideae (Amaryllidaceae)
- Discovery of the chemical constituents, structural characteristics, and pharmacological functions of Chinese caterpillar fungus
- Eco-friendly green approach of nickel oxide nanoparticles for biomedical applications
- Advances in the pharmaceutical research of curcumin for oral administration
- Rapid Communication
- Determination of the contents of bioactive compounds in St. John’s wort (Hypericum perforatum): Comparison of commercial and wild samples
- Retraction
- Retraction of “Two mixed-ligand coordination polymers based on 2,5-thiophenedicarboxylic acid and flexible N-donor ligands: The protective effect on periodontitis via reducing the release of IL-1β and TNF-α”
- Topical Issue on Phytochemicals, biological and toxicological analysis of aromatic medicinal plants
- Anti-plasmodial potential of selected medicinal plants and a compound Atropine isolated from Eucalyptus obliqua
- Anthocyanin extract from black rice attenuates chronic inflammation in DSS-induced colitis mouse model by modulating the gut microbiota
- Evaluation of antibiofilm and cytotoxicity effect of Rumex vesicarius methanol extract
- Chemical compositions of Litsea umbellata and inhibition activities
- Green synthesis, characterization of silver nanoparticles using Rhynchosia capitata leaf extract and their biological activities
- GC-MS analysis and antibacterial activities of some plants belonging to the genus Euphorbia on selected bacterial isolates
- The abrogative effect of propolis on acrylamide-induced toxicity in male albino rats: Histological study
- A phytoconstituent 6-aminoflavone ameliorates lipopolysaccharide-induced oxidative stress mediated synapse and memory dysfunction via p-Akt/NF-kB pathway in albino mice
- Anti-diabetic potentials of Sorbaria tomentosa Lindl. Rehder: Phytochemistry (GC-MS analysis), α-amylase, α-glucosidase inhibitory, in vivo hypoglycemic, and biochemical analysis
- Assessment of cytotoxic and apoptotic activities of the Cassia angustifolia aqueous extract against SW480 colon cancer
- Biochemical analysis, antioxidant, and antibacterial efficacy of the bee propolis extract (Hymenoptera: Apis mellifera) against Staphylococcus aureus-induced infection in BALB/c mice: In vitro and in vivo study
- Assessment of essential elements and heavy metals in Saudi Arabian rice samples underwent various processing methods
- Two new compounds from leaves of Capparis dongvanensis (Sy, B. H. Quang & D. V. Hai) and inhibition activities
- Hydroxyquinoline sulfanilamide ameliorates STZ-induced hyperglycemia-mediated amyleoid beta burden and memory impairment in adult mice
- An automated reading of semi-quantitative hemagglutination results in microplates: Micro-assay for plant lectins
- Inductively coupled plasma mass spectrometry assessment of essential and toxic trace elements in traditional spices consumed by the population of the Middle Eastern region in their recipes
- Phytochemical analysis and anticancer activity of the Pithecellobium dulce seed extract in colorectal cancer cells
- Impact of climatic disturbances on the chemical compositions and metabolites of Salvia officinalis
- Physicochemical characterization, antioxidant and antifungal activities of essential oils of Urginea maritima and Allium sativum
- Phytochemical analysis and antifungal efficiency of Origanum majorana extracts against some phytopathogenic fungi causing tomato damping-off diseases
- Special Issue on 4th IC3PE
- Graphene quantum dots: A comprehensive overview
- Studies on the intercalation of calcium–aluminium layered double hydroxide-MCPA and its controlled release mechanism as a potential green herbicide
- Synergetic effect of adsorption and photocatalysis by zinc ferrite-anchored graphitic carbon nitride nanosheet for the removal of ciprofloxacin under visible light irradiation
- Exploring anticancer activity of the Indonesian guava leaf (Psidium guajava L.) fraction on various human cancer cell lines in an in vitro cell-based approach
- The comparison of gold extraction methods from the rock using thiourea and thiosulfate
- Special Issue on Marine environmental sciences and significance of the multidisciplinary approaches
- Sorption of alkylphenols and estrogens on microplastics in marine conditions
- Cytotoxic ketosteroids from the Red Sea soft coral Dendronephthya sp.
- Antibacterial and biofilm prevention metabolites from Acanthophora spicifera
- Characteristics, source, and health risk assessment of aerosol polyaromatic hydrocarbons in the rural and urban regions of western Saudi Arabia
- Special Issue on Advanced Nanomaterials for Energy, Environmental and Biological Applications - Part II
- Green synthesis, characterization, and evaluation of antibacterial activities of cobalt nanoparticles produced by marine fungal species Periconia prolifica
- Combustion-mediated sol–gel preparation of cobalt-doped ZnO nanohybrids for the degradation of acid red and antibacterial performance
- Perinatal supplementation with selenium nanoparticles modified with ascorbic acid improves hepatotoxicity in rat gestational diabetes
- Evaluation and chemical characterization of bioactive secondary metabolites from endophytic fungi associated with the ethnomedicinal plant Bergenia ciliata
- Enhancing photovoltaic efficiency with SQI-Br and SQI-I sensitizers: A comparative analysis
- Nanostructured p-PbS/p-CuO sulfide/oxide bilayer heterojunction as a promising photoelectrode for hydrogen gas generation